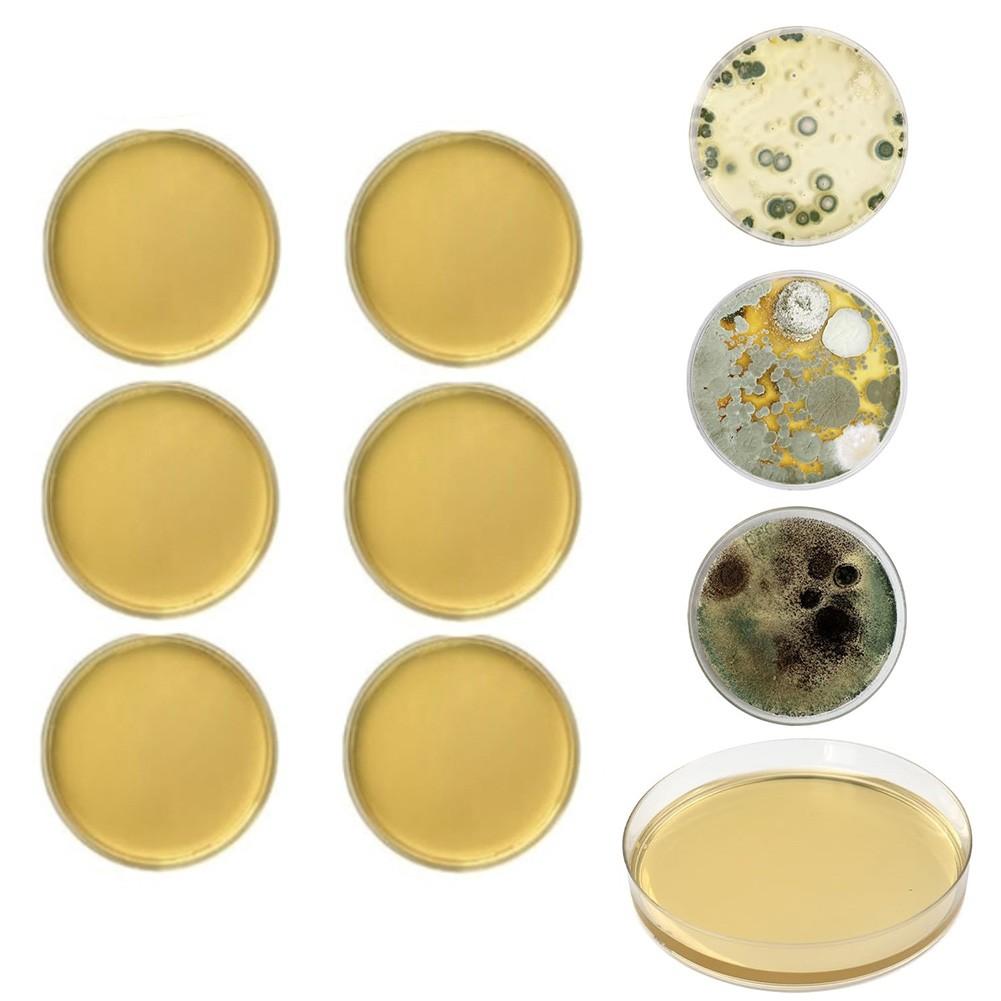
Набор для самостоятельного тестирования на наличие плесени с 10 отдельными тестами на качество воздуха в доме

Соломенный кошелек-клатч для женщин, свадебная вечерняя соломенная сумочка ручной работы, вечерние свадебные летние пляжные плетеные сумки через плечо
Пользователи также просматривали

$4.15
Hockey Tape Racket Exercise Stickers Sports Sticky Protector Cotton Anti-skid Wrapper Glue
aliexpress.com
$6.95
Permanent Toner chip for Pantum M6608N M6608NW P-2500N P-2500NW P-2500W M-6500N M-6500W M-6500NW M-6500nwe M-6550N M-6550W M6550
aliexpress.ru
$2.76
30 Pcs Office Cork Board Butterfly Pushpin Supplies Colorful Butterflies Thumb Tacks Portable Photo Wall Pushpins
aliexpress.com
$0.33
Durable Spring Clips 10pcs 6mm Black For Tent Functional Locking Tube Metal Paddle Pole Professional Push Clip
aliexpress.com
$42.65
Men Pointed Elegant Boots Winter Men Fashion Ankle Boots Slip-On Business Casual Man Party Luxury Designer Shoes
aliexpress.com
$10.40
Платье-комбинация женское, модал, Нижняя юбка, длинное черное белое платье-комбинация, Халат
aliexpress.com
$1.46
10Pcs/lot Artificial Butterflies Garden Decoration Outdoor 3D Simulation Butterfly Stakes Yard Plant Lawn Decor Stick
aliexpress.com
$8.69
Magic Calligraphy That Can Be Reused Handwriting Copybook Set for Kid Calligraphic Letter numbers A B C
aliexpress.com
$11.09
H053 7Pcs Various Shapes Different Number of Faces Educational Toys Digital Number Metal Dice with Box For Party Family Games
aliexpress.com
$26.88
Autumn And Winter New Leopard Pattern Stitching Slim Fit Fashionable Stand Collar Leisure Thin Foreign Style Knitted Suit
aliexpress.com
$14.33
European and American New Style Spring and Autumn Print Women's Sweater Dress Fashion Pure Color Bag Hip Ladies Mini Dress XL
aliexpress.com
$10.45
4Pcs PU Skateboard Wheels 52mmx32mm 95A High-Density 8Pcs Bearings Skate Wheel for Skateboard
aliexpress.com
$17.29
women's swimwear bikini set two-piece suit swimsuit 2021 solid halter hollow out push up low waist polyester beachwear, White;black
dhgate.com
$28.99
28mm Exhaust Pipe Muffler Clamp For 50cc 110 125cc Quad Dirt Pit Bike ATV Sliver
aliexpress.com
$24.15
wedding rings simple love heart shape white gold color copper with zircon jewelry women for engagement party, Slivery;golden
dhgate.com
$16.26
men's swimwear mesh swimsuit men with push-up low rise swimming shorts for running sports surffing mens swim briefs
dhgate.com
$48.69
casual dresses aibeautyer 2021 knitted high waist pearl vintage fashionable elegant lady long autumn winter women, Black;gray
dhgate.com
$17.50
FAKUNTN Free Size Body Waist Trainer Short for Women Men Sweat Slimming Belt Wraps Weight Loss Sauna Belt Waist Support Long
aliexpress.com
$3.02
Hippo Hug Original Drawing Square Pillowcase Polyester Linen Velvet Printed Zip Decor Throw Pillow Case Home Cushion Cover 18"
aliexpress.com
$103.13
women's two piece pants navy knitted tracksuit women loose knitting suit bright silk pullover sweater pencil set female sports out, White
dhgate.com
$17.01
Men sneakers summer fashion elastic band men casual shoes breathable mesh boat shoes non-slip men footwear beach shoes
aliexpress.com
$4.33
Ruler Compass Map Magnifier Hiking Survival Multifunction Camping Portable Lanyard Outdoor
aliexpress.com
$19.18
289Pcs WW2 Military Germany Army Air Forces BF-109 Fighter Plane Model Building Blocks Sets Kit DIY creative Bricks Kids Toys
aliexpress.com
$11.47
13 Pieces Airbrush Adapter Set, Including Airbrush Adapter Kit Airbrush Quick Release Disconnect Fitting Connector Set
aliexpress.com
$4.97
2 Pieces Women's Sexy High Waisted Bikini Set Solid Color Swimsuit Bathing Suit Swimwear For Vacation
aliexpress.com
$0.41
Foldable Tablet Mobile Phone Desktop Phone Stand for iPad iPhone Samsung Desk Holder Adjustable Desk Bracket Smartphone Stand
aliexpress.com
$2.52
800LM Lights Car Lamps Backup 6.6W 2pcs 6000K White T20 33SMD LED Turn light Reverse light
aliexpress.com
$267.85
one-piece suits 5xl-l large swimwear for women plus size swimdress+swim briefs two pieces swimsuit set green purple fashion tankini beachwea
dhgate.com
$13.14
2Pcs Metal Pickups Double Coil Bridge Neck Humbucker Pickups for Electric Guitar Accessories
aliexpress.com
$20.00
3-14 Pullover Impostor Among Us New Hoodie Boys Girl Long Sleeve Sweatshirts kid Streetwear Haraju Cut unicorn printing pattern
aliexpress.com
$25.04
Lovely Rabbit Soft Microfiber Baby Infant Small Bath Towel Newborn Absorbent Drying Washcloth Feeding Cloth Toalha 25x50cm
aliexpress.com
$2.73
3Pcs Newborn Baby Boys Clothes Cotton Romper Long Sleeve Tops Pants Legging Caps Autumn Outfit Clothes Set
aliexpress.com
$4.47
Metal Trimmer Head Durable Tools Accessories Brush Cutter With String Lawn Mower Replacement Grass Parts Home Garden Outdoor
aliexpress.com
$16.61
fitness ale women pink rosed gold print high leggings high waist women sportwear clothes black new leggins, Black;white
dhgate.com
$18.38
Набор для самостоятельного тестирования на наличие плесени с 10 отдельными тестами на качество воздуха в доме
joom.ru














